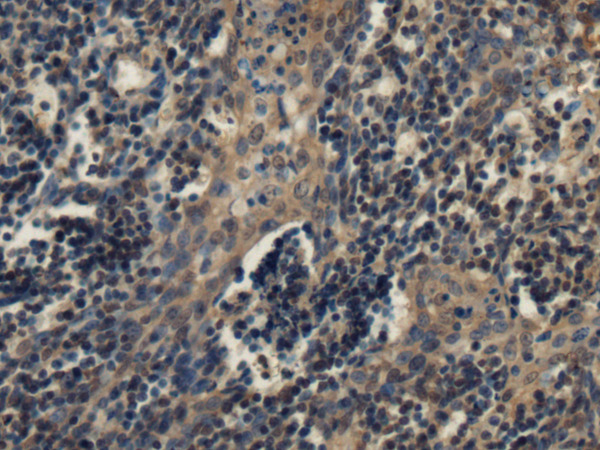
一抗

中文名稱: 兔抗PDGFD多克隆抗體
英文名稱: Anti-PDGFD rabbit polyclonal antibody
別 名: platelet derived growth factor D; IEGF; SCDGFB; MSTP036; SCDGF-B
相關(guān)類別: 一抗
儲(chǔ) 存: 冷凍(-20℃)
宿 主: Rabbit
抗 原: PDGFD
反應(yīng)種屬: Human, Mouse, Rat
標(biāo) 記 物: Unconjugate
克隆類型: rabbit polyclonal
技術(shù)規(guī)格
|
Background: |
The protein encoded by this gene is a member of the platelet-derived growth factor family. The four members of this family are mitogenic factors for cells of mesenchymal origin and are characterized by a core motif of eight cysteines, seven of which are found in this factor. This gene product only forms homodimers and, therefore, does not dimerize with the other three family members. It differs from alpha and beta members of this family in having an unusual N-terminal domain, the CUB domain. Two splice variants have been identified for this gene. [provided by RefSeq, Jul 2008] |
|
Applications: |
ELISA, IHC |
|
Name of antibody: |
PDGFD |
|
Immunogen: |
Fusion protein of human PDGFD |
|
Full name: |
platelet derived growth factor D |
|
Synonyms: |
IEGF; SCDGFB; MSTP036; SCDGF-B |
|
SwissProt: |
Q9GZP0 |
|
ELISA Recommended dilution: |
5000-10000 |
|
IHC positive control: |
Human esophagus cancer and Human tonsil |
|
IHC Recommend dilution: |
100-200 |


 購物車
購物車 幫助
幫助
 021-54845833/15800441009
021-54845833/15800441009